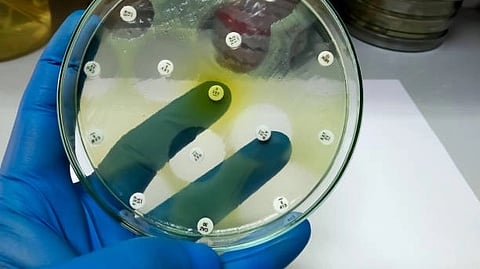

With antibiotic-resistant bacteria on the rise, scientists have been searching for ways to shut down the Type IV secretion system (T4SS), a protein complex on the outer envelope of bacterial cells that helps them to exchange DNA with neighboring bacteria and resist antibiotics.
Now a collaboration between UT Southwestern computational biologist Qian Cong, Ph.D., and molecular biologists at the University of London has elucidated the structure of the T4SS complex, providing a blueprint that could help researchers design drugs that slow development of antibiotic resistance.
The team in London was led by Gabriel Waksman, Ph.D., whose lab has been working for more than two decades to understand T4SS, especially how it forms a thin, hollow structure called a pilus, which connects to nearby bacteria to share genes. For this project, his team used cryo-electron microscopy (cryo-EM) – a process that freezes proteins and uses beams of electrons to obtain high-resolution microscopic images – to elucidate the structure of T4SS. This was no small feat since the T4SS complex is larger than 99.6% of all those included to date in the worldwide library of protein structures.
Dr. Cong then used her background in statistics and machine learning to analyze T4SS protein sequences from several bacteria to generate structural predictions, which were compared to the cryo-EM data. Her computational analysis supported the cryo-EM data and suggested a hypothesis about the function of T4SS. While it was already known that T4SS is involved in pilus assembly, she predicted how it occurs. With that prediction in hand, Dr. Waksman’s team was able to make specific mutations within the relevant pieces of the complex and validate Dr. Cong’s hypothesis in live bacteria.
In addition to the contribution we have made toward the development of drugs to slow the spread of antibiotic resistance genes, this study showcases the power of modern computational methods to validate experimental results and suggest functional insights beyond available experimental data,” said Dr. Cong, a Southwestern Medical Foundation Scholar in Biomedical Research. (NS/ Newswise)